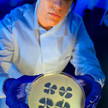
Carbapenem Resistant Enterobacteriaceae cdc melissa dankel EMA empfiehlt neuen β-Lactamase-Hemmer

Thema: neue AM
Artikel zum Thema
Morbus Crohn Zwei neue Wirkstoffe in Sicht
Anhaltender Durchfall und krampfartige Bauchschmerzen: Mehr als 400.000 Menschen in Deutschland leiden an Morbus Crohn, viele von ihnen bereits seit dem jungen... Mehr»
Parkinsonsmittel Opicapon: Neuer COMT-Hemmer
Ein neuer COMT–Hemmer soll zur Behandlung von Parkinsonpatienten im Endstadium zugelassen werden: Ongentys (Opicapon) verlängert die Wirkdauer von Levodopa und... Mehr»
Lungenhochdruck Zulassung für Uptravi
Patienten mit pulmonaler arterieller Hypertonie (PAH) steht ab sofort eine neue Behandlungsoption zur Verfügung: Nach der Empfehlung durch die Europäische... Mehr»
Malaria Gates hofft auf Mosquirix
Mehr als 200 Millionen Menschen haben sich im vergangenen Jahr mit Malaria angesteckt. Vor allem in Afrika sterben viele an der Krankheit. Die Bill & Melinda... Mehr»
Antiscabiosa Ivermectin als Tablette zugelassen
Infectopharm hat hierzulande die erste Ivermectin-haltige Tablette auf den Markt gebracht. Scabioral ist seit Mai erhältlich. Die orale Darreichungsform des... Mehr»
MS-Medikamente Zweite Chance für Daclizumab
Daclizumab kommt zurück: Der humanisierte monoklonale Antikörper gegen den Interleukin-2-Rezeptor CD25 (IL-2Ra) soll eingesetzt werden bei erwachsenen Patienten... Mehr»
Antibiotika EMA empfiehlt neuen β-Lactamase-Hemmer
Die Europäische Arzneimittelagentur (EMA) hat ein neuartiges Antibiotikum zur Zulassung empfohlen: Zavicefta enthält das generische β-Lactam-Antibiotikum... Mehr»
Neue Arzneimittel Zulassung für Taltz und Lonsurf
Zwei neue Medikamente können ab sofort in Europa vermarktet werden: Die EU-Kommission erteilte die Zulassung für das Psoriasis-Medikament Taltz (Ixekizumab,... Mehr»
Arzneimittelforschung Innovationen: Kleine (Fort)schritte
Wann ist ein neues Arzneimittel eine Innovation? Während einige Experten schon eine Verbesserung der Galenik als Durchbruch feiern, sehen andere darin lediglich... Mehr»
Lipidsenker PCSK9-Hemmer: Statine waren gestern
Zu hohe Blutfettwerte sind ein Risikofaktor für Herzinfarkt und Schlaganfall. Eine neue Wirkstoffklasse, die PCSK9-Inhibitoren, soll bereits nach wenigen Wochen... Mehr»
Medien zum Thema
- 1